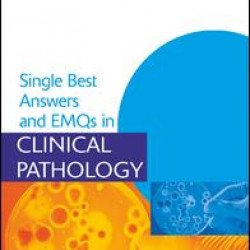
Single Best Answers and EMQs in Clinical Pathology Single Best Answers and EMQs in Clinical Pathology

Pathology
Brand: Taylor & Francis
Model: Stock
Spanning a wide array of topics relating to the diagnosis and treatment of cerebrovascular disease, this reference collects the latest studies and recommendations from a team of 75 leading authorities on the subject-including the management of subarachnoid hemorrhage, the treatment of acute ischemic..
₹12,852.00 ₹16,064.99
Brand: Taylor & Francis
Model: 9780340731574
Paediatric Forensic Medicine and Pathology..
₹18,727.19 ₹23,408.99
Brand: Taylor & Francis
Model: 9780340959046
This self-assessment volume is a companion to Basic Pathology: An Introduction to the Mechanisms of Disease, Fourth Edition. Featuring 50 illustrated clinical scenarios with questions and answers, the book helps readers learn to apply their knowledge to clinical situations. Each vignette stems from ..
₹2,569.66 ₹3,212.08
Brand: Taylor & Francis
Model: 9780340809686
Pathology of Melanocytic Disorders is the most comprehensive account of the pathology of cutaneous and non-cutaneous melanocytic lesions. This second edition is fully updated and maintains the high standards set by the successful first edition...
₹22,031.99 ₹27,539.99
Brand: Taylor & Francis
Model: Stock
Procedure Manual for the Diagnosis of Intestinal Parasites is the definitive resource for individuals involved in the collection, preparation, and examination of fecal specimens for microscopic diagnosis of intestinal parasitic infections. The book points out the stages of parasites possibly found i..
₹11,383.20 ₹14,229.00
Brand: Taylor & Francis
Model: Stock
Written to improve laboratory work, this volume also examines logistic and legal tools related to quality issues. Authored by researchers long involved with theoretical and practical laboratory activity, the book begins with selected aspects of quality assurance applied in laboratory medicine and to..
₹4,552.54 ₹5,690.68
Brand: Taylor & Francis
Model: Stock
Single Best Answers and EMQs in Clinical Pathology..
₹8,812.80 ₹11,016.00
Brand: Taylor & Francis
Model: Stock
Tissue stem cells and their medical applications have become a major focus of research over the past decade. With 16 full-color illustrations, this reference provides a thorough and up-to-date overview of the current and emerging technologies for stem cell research and transplantation. Divided into ..
₹12,117.60 ₹15,146.99
Brand: Taylor & Francis
Model: Stock
Understanding Pathology: From Disease Mechanism to Clinical Practice..
₹4,772.86 ₹5,966.08
Showing 1 to 10 of 10 (1 Pages)